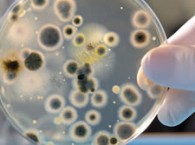
2010-07-09-dispositivo_ik4_med

-
The winning group will be responsible for the engineering and manufacture of 10 large superconducting coils for the reactor, which...
-
With 50 years of experience in packaging and more than 15 with blister packaging, ULMA has unveiled an automatic packaging...
-
This is the most important electronic documentation and biometrics project in Latin America, and consolidates the position of the company...
-
The Vlake tunnel, located in Zeeland, Holland, has employed LED luminaires technology since June from the company Indal. This is...
-
The opening of the 50 MW La Florida plant, located in Alvarado (Badajoz), makes Spain the global leader in solar...
-
The S-80 was completely designed in Spain. It uses an anaerobic propulsion system that is unique in the world, based...
-
The company has to date equipped the control centers for 157 telecommunications satellites, for clients such as Hispasat, Eutelsat, SES...
-
The system, created by Aries Ingeniería y Sistemas, reaches velocities of up to 1,000,000 images per second, depending on the...
-
The portable device is able to detect Chlamydia, the presence of the human papillomavirus (which can cause cancer of the...
-
Tunisia’s national water utility Sonede confirmed this week that a Befesa-led consortium has won a 22-year contract to build, own...
-
The Spanish multinational Indra has developed the ABC System, a passport control system that combines document authentication with a double...
-
President Barack Obama announced on July 3rd that the US Government will grant a federal loan guarantee worth $1,450 million...
-
The Valencia company NeoDuction has developed Relisten, a technology that reproduces sound in three dimensions (3D), otherwise called immersion.
-
Navantia has developed the COMPLEX application for the implementation of the Integrated Platform Management System, which controls the platform for...
-
The “Micromanufacturing” project is developing an impressive range of technologies for the manufacture of components on a micrometric scale.